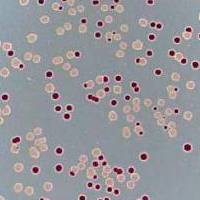
Колонии Escherichia coli в чашке Петрина среде из агара, содержащего арабинозу

Долгосрочный эволюционный эксперимент на бактериях Escherichia coli, продолжающийся уже почти 30 лет, дал новые неожиданные результаты. Секвенирование ДНК бактерий из замороженной «ископаемой летописи» эксперимента показало, что за 60 000 поколений эволюция подопытных популяций не прекратилась и даже не замедлилась. Как минимум в 9 популяциях из 12 произошла экологическая диверсификация: исходная монокультура подразделилась на клады, связанные экологическими взаимодействиями и не вытесняющие друг друга. Внутри каждой клады эволюция продолжается полным ходом, причем дальнейшие изменения направляются как предшествующей эволюционной историей, так и меняющейся экологической обстановкой. Таким образом, эволюция «перехитрила» исследователей, надеявшихся изучить действие мутаций и отбора в ходе адаптации к стабильным условиям в предельно простой искусственной системе.
«Элементы» не раз рассказывали о долгосрочном эволюционном эксперименте, начатом в 1988 году Ричардом Ленски (см. ссылки в конце новости). В ходе эксперимента 12 исходно одинаковых популяций кишечной палочки Escherichia coli в течение вот уже более 60 000 поколений культивируются в одних и тех же условиях: в жидкой питательной среде, где единственным источником пищи является глюкоза. Правда, одна из популяций, Ara-3, научилась употреблять в пищу ещё и цитрат, присутствующий в среде в качестве вспомогательного вещества (см.: В долгосрочном эксперименте зафиксировано поэтапное формирование эволюционного новшества, «Элементы», 25.09.2012). Раз в сутки из каждой популяции берут небольшую часть (примерно 107 клеток) и пересаживают в свежую питательную среду, где бактерии сначала быстро размножаются, а потом, по мере исчерпания глюкозы, рост численности замедляется. Каждые 500 поколений часть бактерий из каждой популяции замораживают для последующего изучения. Микробы при этом сохраняют жизнеспособность. Таким образом, в распоряжении исследователей имеется «живая палеонтологическая летопись» эксперимента.
Хотя условия эксперимента выглядят предельно простыми, многие его результаты оказались неожиданными. Например, логично было бы предположить, что после непродолжительного периода быстрой адаптации (роста приспособленности) к новым условиям популяции достигнут оптимума (поднимутся на пик ландшафта приспособленности, см. Fitness landscape), запас возможных полезных мутаций будет исчерпан, изменения замедлятся и наступит неопределенно долгий период эволюционного стазиса. Не тут-то было: даже после 50 000 поколений полезные мутации всё ещё появлялись, а приспособленность продолжала расти, хоть и с замедлением (см.: Новые результаты долгосрочного эволюционного эксперимента: приспособленность подопытных бактерий продолжает расти, «Элементы», 23.12.2013).
Эксперимент изначально был спланирован таким образом, чтобы свести к минимуму все осложняющие обстоятельства, такие как изменения условий среды, генетический обмен и экологические взаимодействия между организмами. Исследователи хотели получить в чистом виде самый простой и фундаментальный эволюционный процесс — адаптацию к стабильной среде на основе мутаций и отбора. Однако, как метко заметил Лесли Оргел (Leslie Orgel), «эволюция умнее, чем ты» (см.: Orgel's rules). Новая статья Ленски и его коллег, опубликованная 18 октября в журнале Nature, показывает, что избежать сложностей все-таки не удалось. Как выяснилось, в подопытных популяциях сами собой зарождаются экологические взаимодействия, основанные на диверсификации и разделении ниш, что заставляет бактерий приспосабливаться к меняющейся биотической обстановке.
Авторы провели генетический анализ всей замороженной «ископаемой летописи» эксперимента, накопившейся за 60 000 бактериальных поколений и насчитывающей в общей сложности около 1440 проб (по 60 000/500 = 120 проб на каждую из 12 популяций). Для каждой пробы был проведен метагеномный анализ с 50-кратным покрытием (см.: Coverage). Этого оказалось достаточно, чтобы надежно идентифицировать все новые мутации, которые возникали в подопытных популяциях и достигали частоты не менее 10% (то есть встречались как минимум у каждой десятой бактерии) хотя бы в двух пробах. Мутации, не получившие столь широкого распространения, не учитывались, потому что их трудно отличить от случайных ошибок секвенирования.
В итоге получилась детальная реконструкция эволюционного процесса в 12 популяциях (рис. 1). Нужно помнить, что практически все изменения частот аллелей, заметные на рисунке 1, отражают работу естественного отбора, а не генетического дрейфа (случайных колебаний частот аллелей). Дрейф работает гораздо медленнее. Эффективная численность подопытных популяций составляет примерно 107, а при такой численности для того, чтобы новая мутация зафиксировалась (достигла частоты 1) за счет дрейфа, требуется время порядка 107 поколений, то есть в сотни раз больше, чем прошло с начала эксперимента. Все мутации, достигшие заметной частоты в ходе эксперимента, сделали это под действием отбора. Они либо сами были полезны и поддерживались отбором, либо находились в одном геноме с полезной мутацией и распространялись за счет «генетического автостопа» (см.: Genetic hitchhiking), типичного для бесполых популяций (см.: Половое размножение помогает отбору отделять полезные мутации от вредных, «Элементы», 01.03.2016).
Как уже говорилось, рост общей приспособленности (которая оценивается по скорости размножения по сравнению с исходным, предковым штаммом) замедлился, но не прекратился (рис. 2, а; подробнее см. в новости Новые результаты долгосрочного эволюционного эксперимента: приспособленность подопытных бактерий продолжает расти, «Элементы», 23.12.2013). Темп накопления новых мутаций остался высоким (рис. 2, b). В шести из двенадцати популяций зафиксировались аллели-мутаторы (мутации, снижающие точность репликации или репарации), что резко ускорило как появление, так и фиксацию новых мутаций (убегающие вверх графики на рис. 2, b). Впрочем, несколько позже в популяциях с мутаторами стали распространяться аллели-«антимутаторы», снижающие темп мутагенеза. Это видно по замедлению роста числа мутаций в некоторых популяциях с мутаторами (врезка на рис. 2, b).

Рис. 2. Динамика приспособленности и накопления мутаций в 12 популяциях. а — приспособленность, оцениваемая по скорости размножения бактерий по сравнению с исходным предковым штаммом (подробнее см. в новости: Новые результаты долгосрочного эволюционного эксперимента: приспособленность подопытных бактерий продолжает расти, «Элементы», 23.12.2013). b — среднее число накопленных мутаций. Графики, резко уходящие вверх, соответствуют шести популяциям, в которых повысился темп мутагенеза из-за фиксации аллелей-«мутаторов» (мутаций, снижающих точность репликации или репарации). На врезке показана динамика накопления мутаций в шести популяциях с мутаторами. Белой линией показана усредненная динамика для популяций, в которых мутаторы не зафиксировались. Рисунок из обсуждаемой статьи в Nature
Но главное открытие, сделанное авторами, состоит не в этом. Эволюционная динамика, отображенная на рис. 1, не вписывается в простейшую модель, согласно которой адаптивная эволюция монокультуры бесполых организмов в стабильных условиях сводится к последовательной фиксации отбором вновь возникающих полезных мутаций.
Статистическая обработка данных, приведенных на рис. 1, показала, что эта простейшая модель не может объяснить наблюдаемую картину даже с учетом таких осложняющих обстоятельств, как генетический автостоп и клональная интерференция (конкуренция между клонами бактерий с разными полезными мутациями; см.: Clonal interference). Например, многие мутации, достигнув некоторой частоты, вдруг перестают распространяться, то есть двигаться дальше в сторону фиксации (таков естественный ход событий, если клон с данной мутацией имеет более высокую приспособленность, чем другие бактерии в популяции). Но эти клоны и не вымирают, проиграв конкуренцию клонам с более удачными мутациями. Вместо этого частота мутации начинает колебаться вокруг какого-то уровня. Эти колебания могут продолжаться десятки тысяч поколений, причем уровень, вокруг которого происходят колебания, может со временем меняться.
Метагеномные данные, полученные для каждой из 1440 проб, представляют собой множество отсеквенированных кусочков ДНК, принадлежащих разным индивидам. Поэтому нельзя сразу понять, какие мутации относятся к одному и тому же клону, а какие — к разным. Однако авторам удалось разобраться в этом, проанализировав согласованность изменения частот мутаций во времени (поскольку частоты мутаций, находящихся в одном и том же геноме, меняются синхронно). В итоге выяснилось, что по крайней мере в девяти из двенадцати подопытных популяций в течение длительного времени (свыше 10 000 поколений) имело место устойчивое сосуществование как минимум двух клад (эволюционных линий). Внутри этих клад шли свои собственные эволюционные процессы, то есть появлялись и фиксировались различные мутации (рис. 3).
Рис. 3. Длительное сосуществование клад в подопытных популяциях. a — детальная история популяции Ara-6. На верхнем рисунке разными цветами показаны мутации «базальной клады» (basal clade), от которой в дальнейшем произошли «главная» клада (major clade, второй сверху рисунок) и «второстепенная» клада (minor clade, третий рисунок). Какая из клад считалась главной, а какая второстепенной, зависело от их численности в конце периода наблюдений. На нижнем рисунке показана судьба вымерших мутаций. — история всех двенадцати популяций, в девяти из которых удалось установить сосуществование двух клад (фиолетовая и розовая линии). Изображение из обсуждаемой статьи в Nature
Это значит, что в большинстве подопытных популяций произошла экологическая диверсификация. Разные клады как-то поделили между собой экологические ниши и стали устойчиво сосуществовать, приспосабливаясь теперь уже не к изначально заданным стабильным условиям среды, а к специфическому и переменчивому биотическому окружению.
Данное явление ранее было обнаружено в одной из двенадцати популяций (Ara-2). Две клады, сосуществующие в этой популяции, имеют разный обмен веществ и используют к своей выгоде продукты жизнедеятельности другой клады. Устойчивое сосуществование обеспечивается частотно-зависимым балансирующим отбором. Это значит, что относительная приспособленность клады тем выше, чем ниже ее численность (J. Plucain et al., 2014. Epistasis and allele specificity in the emergence of a stable polymorphism in Escherichia coli). Новые данные показали, что аналогичная ситуация сложилась как минимум в девяти из двенадцати популяций. Таким образом, экологическая диверсификация — не случайный эпизод, а общая закономерность.
Анализ истории отдельных клад показал, что адаптивная эволюция внутри клад продолжает идти полным ходом: появляются новые полезные (для данной клады) мутации, их частоты растут под действием отбора, вместе с ними распространяются «автостопом» другие (не такие полезные) мутации; многие генетические варианты, достигнув заметной частоты, впоследствии вымирают, вытесненные более удачливыми конкурентами. И всё это происходит уже не в масштабах всей подопытной популяции, а по отдельности в каждой из клад. Поэтому отчасти теряет смысл оценка приспособленности бактерий по скорости их роста по сравнению с предковым штаммом (рис. 2, а): ведь теперь их реальная приспособленность зависит еще и от того, насколько успешно они взаимодействуют с представителями сосуществующих клад.
Статистический анализ распределения мутаций во времени показал, что в одних генах мутации преимущественно фиксировались в начале эксперимента (на ранних этапах адаптации), тогда как в других генах мутации начали фиксироваться лишь на поздних этапах. Это объясняется тремя причинами, причем все три, по мнению авторов, реально работают в ходе эксперимента (строго доказать это пока нельзя, но есть косвенные статистические аргументы в пользу реальности всех трех причин).
Во-первых, мутации в некоторых генах наиболее выгодны (дают наибольшую прибавку приспособленности) для исходного генотипа, и поэтому такие мутации фиксируются первыми, вытесняя в ходе клональной интерференции другие, менее полезные мутации в других генах. Эти последние начинают распространяться позже, когда первая порция самых «очевидных» полезных мутаций уже зафиксировалась.
Во-вторых, мутации, зафиксировавшиеся ранее, влияют на полезность или вредность мутаций, появляющихся позднее (влияние одних генетических вариантов на фенотипические проявления, в том числе на полезность, других называют эпистазом, см.: Epistasis). Поэтому некоторые мутации становятся полезными и получают шанс зафиксироваться только после того, как благодаря другим мутациям сформируется подходящий генетический контекст (см.: Эволюция белков сдерживается низкой проходимостью ландшафта приспособленности, «Элементы», 09.02.2015). Именно так обстояло дело с мутацией, благодаря которой бактерии из популяции Ara-3 получили возможность питаться цитратом (см.: В долгосрочном эксперименте зафиксировано поэтапное формирование эволюционного новшества, «Элементы», 25.09.2012).
В-третьих, формирующиеся экологические взаимодействия между кладами в корне меняют «правила игры», заставляя бактерий приспосабливаться уже не к стабильной и предельно простой среде (как было задумано исследователями), а к динамичному биотическому окружению. Это значит, что направленность отбора всё время меняется, и поэтому мутации, полезные для данной клады в данный момент, вовсе не обязательно будут полезными в другое время или для других клад.
Таким образом, долгосрочный эволюционный эксперимент опроверг чрезмерно упрощенные представления о том, как должна идти адаптация бесполой популяции к стабильным условиям среды. Ничего похожего на замедление и остановку адаптивной эволюции по мере приближения к оптимуму (пику на ландшафте приспособленности) не наблюдается, запас потенциально полезных мутаций не исчерпывается, и даже темп их накопления практически не снижается. Вместо этого мы видим самопроизвольное усложнение эволюционирующего сообщества, которое из монокультуры превращается в экосистему с подразделенными нишами и коэволюционирующими кладами и явно не собирается в обозримом будущем переходить в состояние эволюционного стазиса. Так что Лесли Оргел был, конечно, прав насчет того, кто умнее — эволюция или теоретики, считающие, что всё про нее знают.
Источник: Benjamin H. Good, Michael J. McDonald, Jeffrey E. Barrick, Richard E. Lenski & Michael M. Desai. The dynamics of molecular evolution over 60,000 generations // Nature. Published online 18 October 2017. DOI: 10.1038/nature24287.
См. также:
1) Подведены итоги эволюционного эксперимента длиной в 40 000 поколений, «Элементы», 01.11.2009.
2) В долгосрочном эволюционном эксперименте выявлен отбор на «эволюционную перспективность», «Элементы», 25.03.2011.
3) В долгосрочном эксперименте зафиксировано поэтапное формирование эволюционного новшества, «Элементы», 25.09.2012.
4) Новые результаты долгосрочного эволюционного эксперимента: приспособленность подопытных бактерий продолжает расти, «Элементы», 23.12.2013.
5) Способы адаптации бактерий к разным температурам оказались предсказуемыми, «Элементы», 16.03.2017.

Рис. 1. Ход молекулярной эволюции в 12 популяциях кишечной палочки. Показаны изменения частоты встречаемости всех зарегистрированных новых мутаций. По горизонтальной оси — время в поколениях. Рисунок из обсуждаемой статьи в Nature